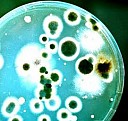
Дезинсекция подвалов Курган

Дезинсекция подвалов в Кургане
Характеристики:
- 1. Эффективное уничтожение насекомых.
- 2. Обработка подвалов и прилегающих территорий.
- 3. Применение безопасных для людей и домашних животных средств.
- 4. Профессиональный подход к дезинсекции.
- 5. Длительный эффект после обработки.
- 6. Гарантия качества услуг.
Сейчас этот товар просматривают 5 человек.
За последние 30 минут, получено 3 заявки на расчет.
За последние 30 минут, получено 3 заявки на расчет.
Цена:
от
1081
до
1821
руб. за объект
Как оплатить:
Оплата производится пластиковой картой или безналичным переводом, после выставление счета и договора исполнителем или по факту получение заказа или оказания услуги.
Оплата производится пластиковой картой или безналичным переводом, после выставление счета и договора исполнителем или по факту получение заказа или оказания услуги.
Где можно купить?
Перед оформлением заказа, исполнитель согласует с Вами все условия доставки или укажет адрес самовывоза и подберет самый выгодный вариант.
Перед оформлением заказа, исполнитель согласует с Вами все условия доставки или укажет адрес самовывоза и подберет самый выгодный вариант.
Пожалуй, самая низкая цена в области
Мы нашли 4 из 64 исполнителей из г. Курган по данному товару, пожалуй, с лучшей ценой и качеством.
Оставьте заявку, чтобы узнать их цену и получить от каждого подробный расчет.
Настоятельно рекомендуется заключать договор с исполнителем и не переводить денежные средства до получение товара, если у вас есть сомнения относительно его надёжности.
Оставьте заявку, чтобы узнать их цену и получить от каждого подробный расчет.
Настоятельно рекомендуется заключать договор с исполнителем и не переводить денежные средства до получение товара, если у вас есть сомнения относительно его надёжности.
Расчет на Дезинсекция подвалов
Моментальный калькулятор